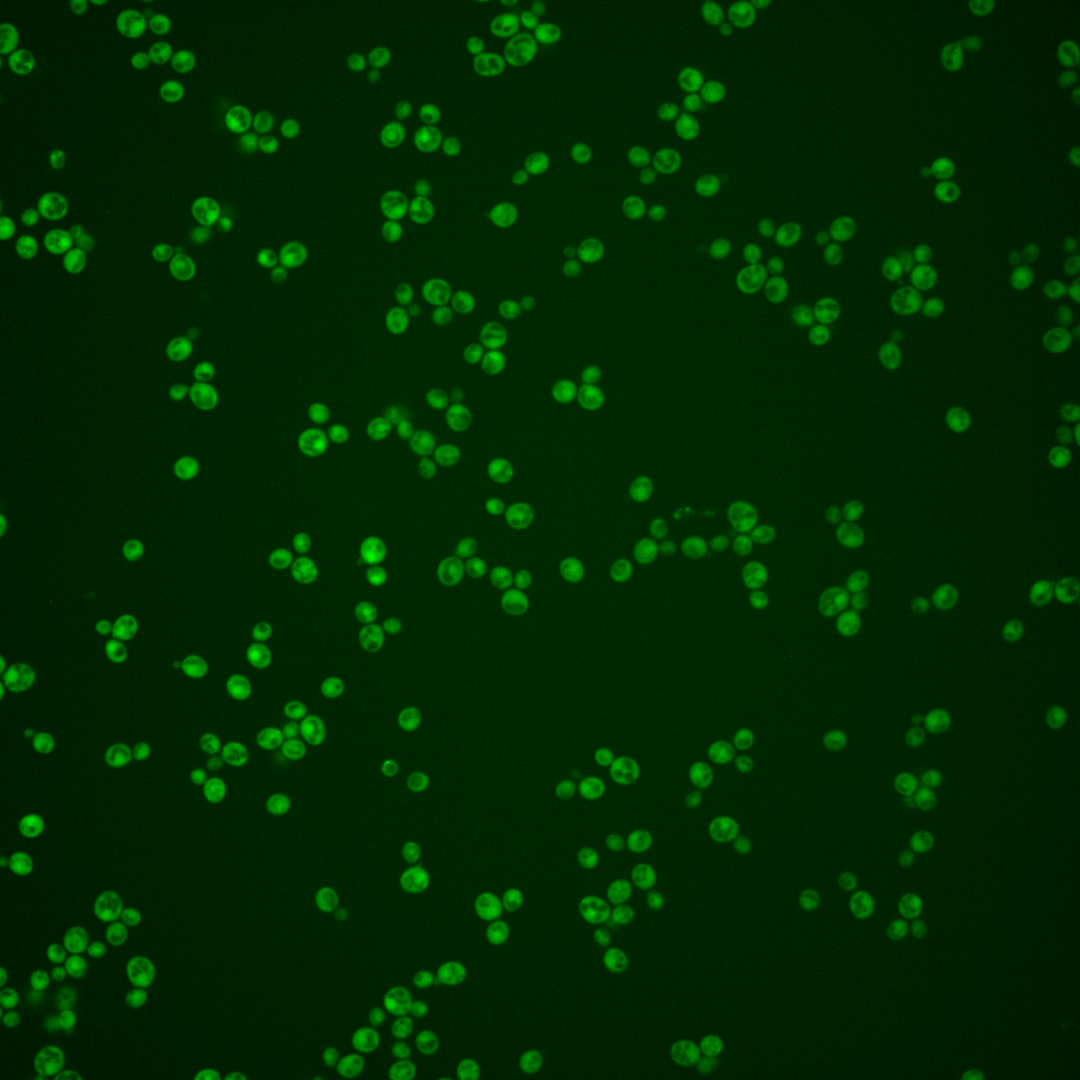
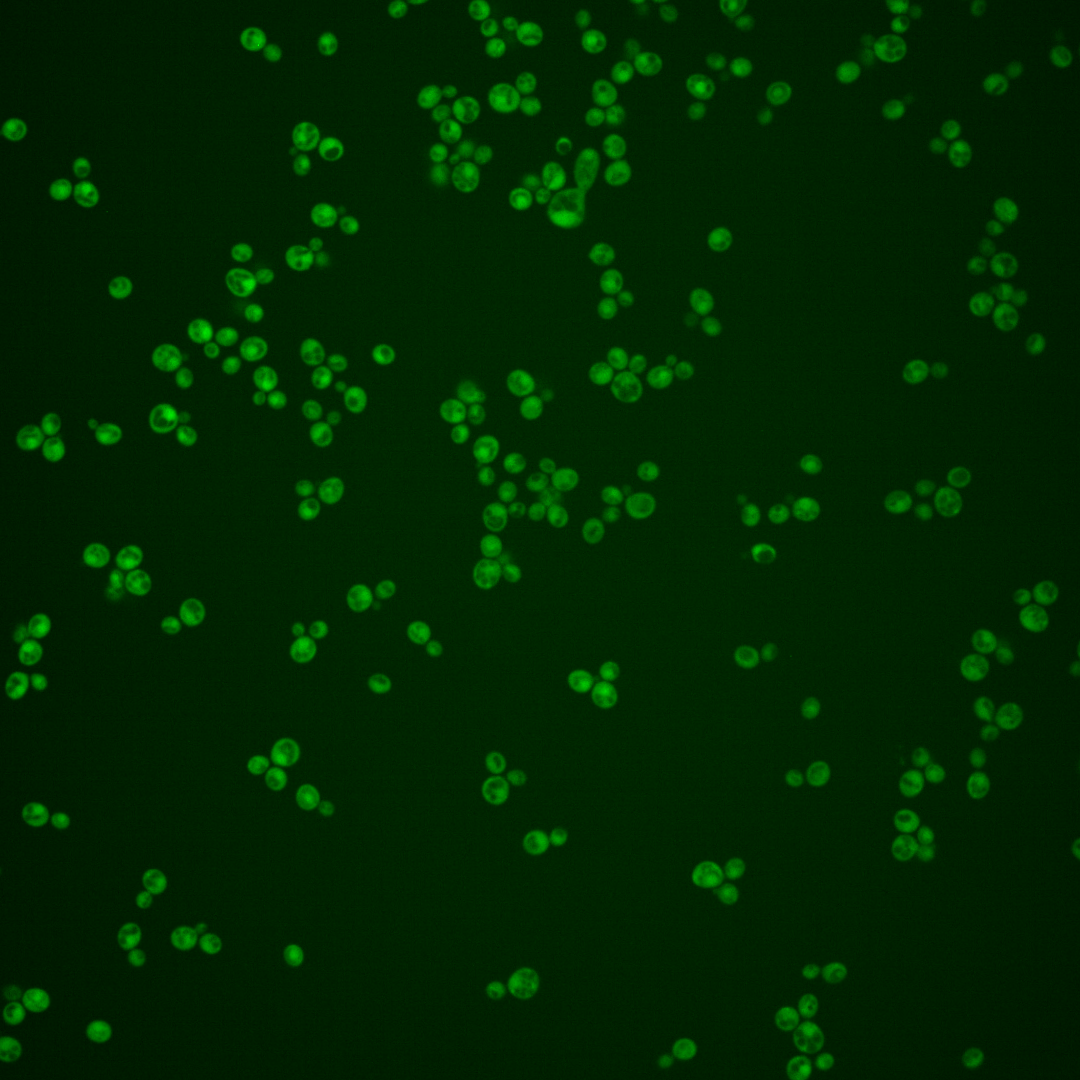
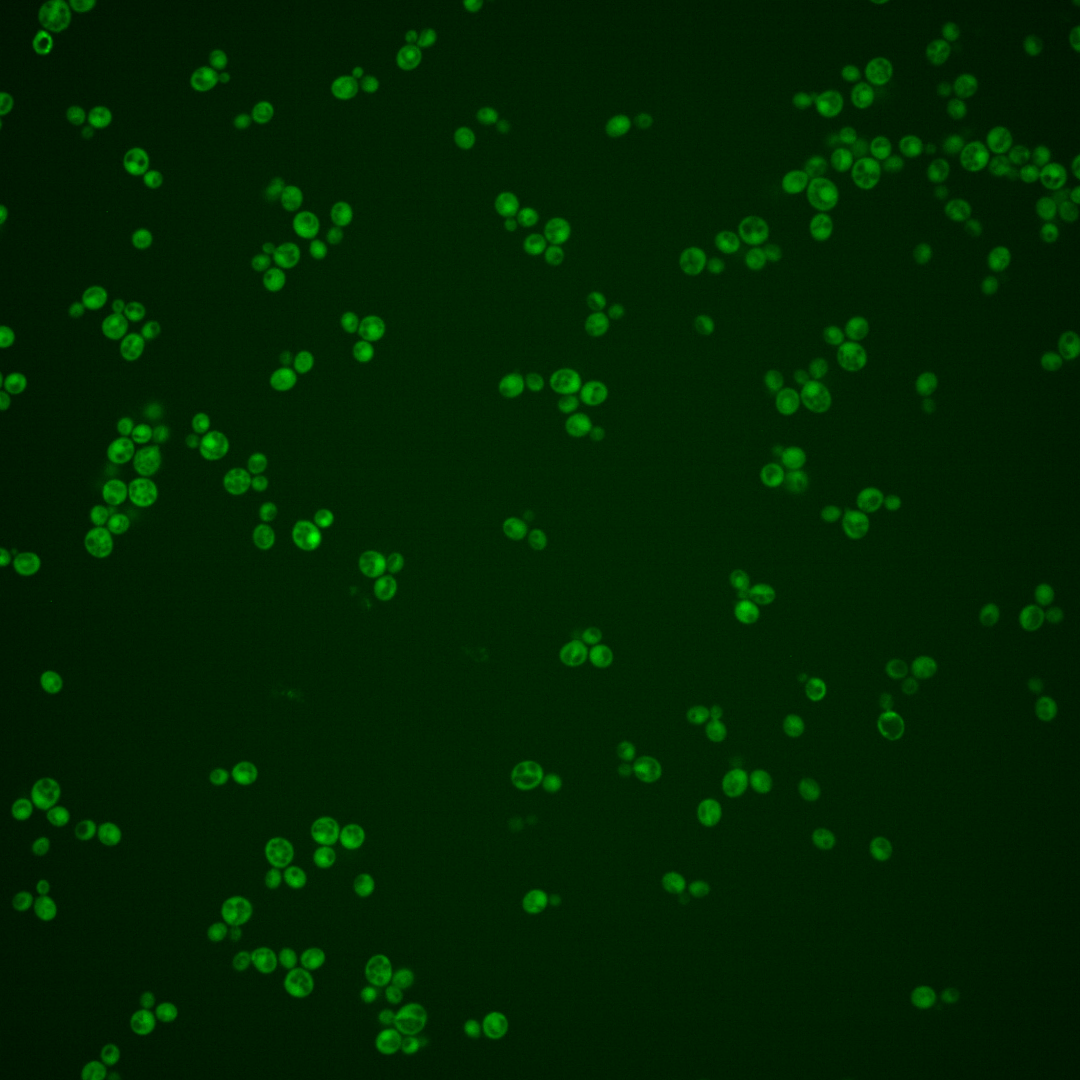
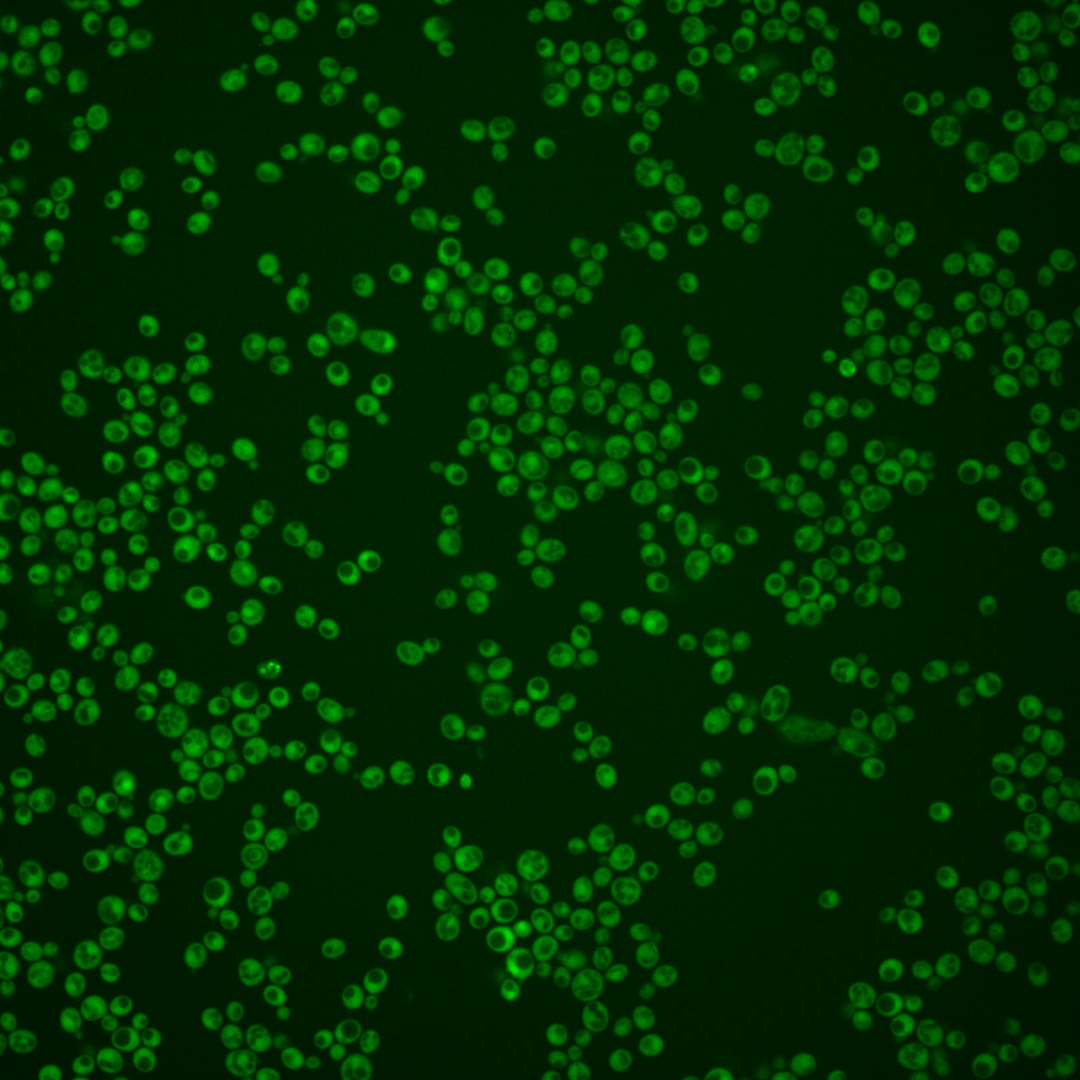
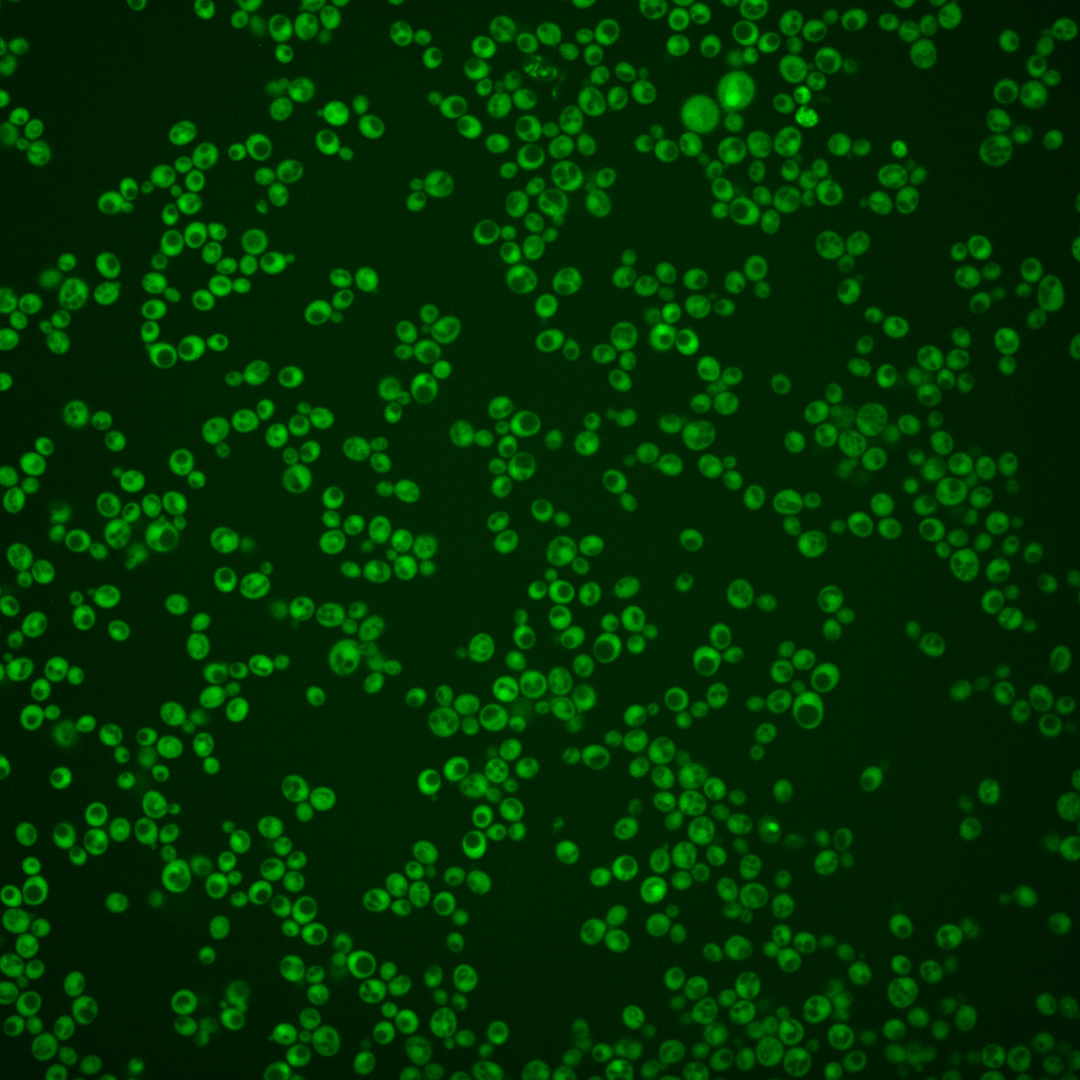
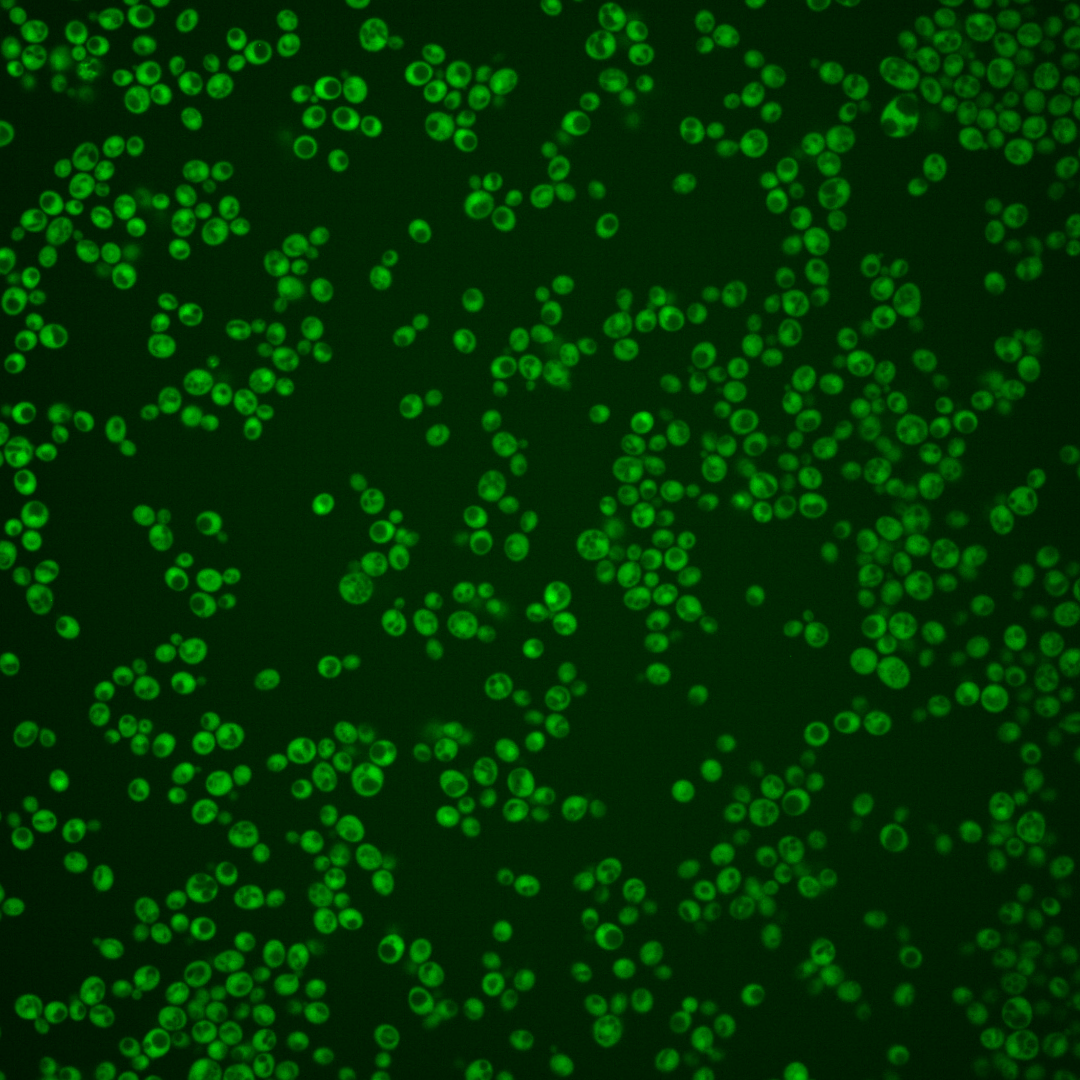
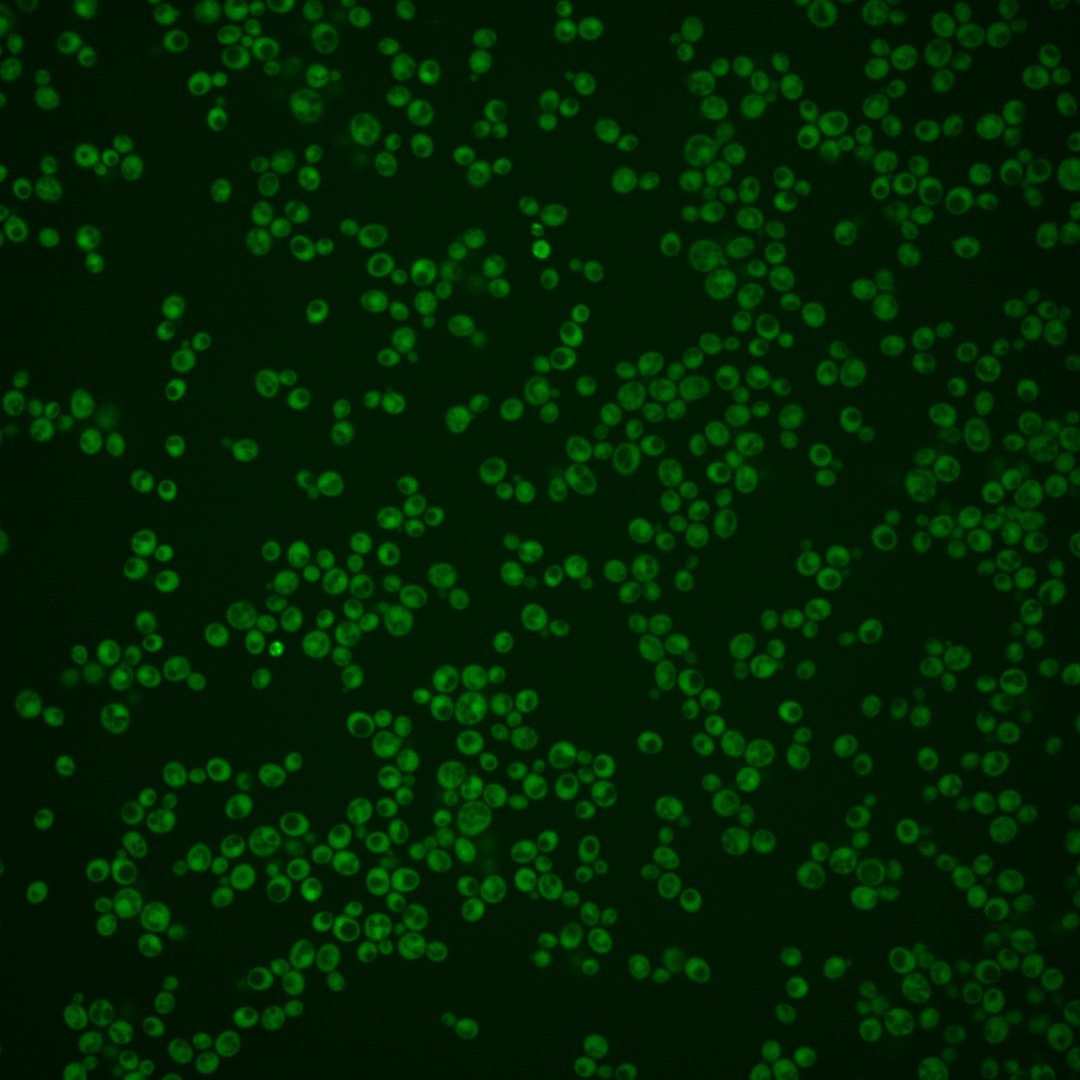

| ORF | |
|---|---|
| Human Ortholog | |
| Description | Putative protein of unknown function; green fluorescent protein (GFP)-fusion protein localizes to both the cytoplasm and the nucleus |
Micrographs




















































































Sub-cellular Localization
Yeast GFP Assignment
Protein Abundance
Localization Change
External localization resources
| ensLOC | DeepLoc | |||||||||||||||||||||||
|---|---|---|---|---|---|---|---|---|---|---|---|---|---|---|---|---|---|---|---|---|---|---|---|---|
| Localization | WT1 | WT2 | WT3 | RAP60 | RAP140 | RAP220 | RAP300 | RAP380 | RAP460 | RAP540 | RAP620 | RAP700 | HU80 | HU120 | HU160 | rpd3Δ_1 | rpd3Δ_2 | rpd3Δ_3 | WT1 | WT2 | WT3 | AF100 | AF140 | AF180 |
| Cortical Patches | 0 | 0 | 0 | 0 | 0 | 0 | 0 | 0 | 0 | 0 | 0 | 1 | 0 | 0 | 0 | 0 | 0 | 0 | 0 | 1 | 2 | 0 | 0 | 2 |
| Bud | 0 | 0 | 2 | 0 | 1 | 0 | 6 | 2 | 11 | 7 | 11 | 4 | 0 | 0 | 0 | 0 | 2 | 0 | 0 | 0 | 0 | 0 | 0 | 2 |
| Bud Neck | 0 | 0 | 0 | 0 | 0 | 0 | 0 | 0 | 0 | 0 | 0 | 0 | 0 | 0 | 0 | 0 | 0 | 0 | 0 | 0 | 0 | 0 | 0 | 0 |
| Bud Site | 0 | 0 | 0 | 0 | 0 | 0 | 0 | 0 | 0 | 0 | 1 | 0 | 0 | 0 | 0 | 0 | 0 | 0 | – | – | – | – | – | – |
| Cell Periphery | 0 | 0 | 4 | 2 | 1 | 1 | 6 | 2 | 1 | 1 | 4 | 5 | 0 | 1 | 0 | 6 | 4 | 10 | 0 | 0 | 0 | 0 | 0 | 0 |
| Cytoplasm | 109 | 157 | 218 | 215 | 268 | 285 | 328 | 331 | 250 | 267 | 167 | 276 | 270 | 407 | 379 | 171 | 135 | 122 | 103 | 156 | 204 | 55 | 227 | 235 |
| Endoplasmic Reticulum | 0 | 1 | 5 | 0 | 0 | 1 | 1 | 0 | 0 | 4 | 0 | 9 | 3 | 3 | 1 | 5 | 0 | 3 | 0 | 0 | 2 | 0 | 0 | 0 |
| Endosome | 0 | 0 | 0 | 0 | 1 | 2 | 0 | 0 | 3 | 0 | 0 | 1 | 0 | 1 | 0 | 1 | 1 | 0 | 0 | 1 | 0 | 1 | 0 | 1 |
| Golgi | 0 | 0 | 2 | 1 | 0 | 0 | 0 | 0 | 0 | 0 | 0 | 0 | 0 | 0 | 0 | 1 | 1 | 0 | 1 | 1 | 1 | 0 | 0 | 0 |
| Mitochondria | 6 | 2 | 1 | 9 | 13 | 50 | 118 | 113 | 132 | 181 | 160 | 227 | 0 | 0 | 0 | 3 | 0 | 2 | 0 | 0 | 0 | 0 | 0 | 2 |
| Nucleus | 0 | 0 | 0 | 0 | 3 | 3 | 8 | 8 | 9 | 9 | 3 | 9 | 0 | 1 | 3 | 4 | 0 | 3 | 0 | 0 | 0 | 1 | 0 | 1 |
| Nuclear Periphery | 0 | 0 | 0 | 0 | 2 | 2 | 0 | 1 | 0 | 3 | 2 | 5 | 0 | 0 | 0 | 0 | 0 | 0 | 0 | 0 | 0 | 0 | 0 | 0 |
| Nucleolus | 0 | 0 | 0 | 1 | 0 | 0 | 1 | 0 | 1 | 1 | 0 | 0 | 0 | 0 | 0 | 0 | 0 | 0 | 0 | 0 | 0 | 0 | 0 | 0 |
| Peroxisomes | 0 | 0 | 0 | 0 | 0 | 0 | 0 | 0 | 0 | 0 | 0 | 0 | 0 | 0 | 0 | 0 | 0 | 0 | 0 | 0 | 0 | 0 | 0 | 0 |
| SpindlePole | 0 | 0 | 0 | 0 | 0 | 0 | 0 | 0 | 1 | 0 | 0 | 1 | 0 | 0 | 0 | 0 | 0 | 0 | 0 | 0 | 1 | 0 | 0 | 0 |
| Vac/Vac Membrane | 0 | 0 | 1 | 2 | 4 | 18 | 22 | 43 | 59 | 42 | 34 | 28 | 1 | 4 | 6 | 4 | 9 | 5 | 0 | 0 | 1 | 1 | 0 | 1 |
| Unique Cell Count | 112 | 160 | 226 | 219 | 279 | 325 | 413 | 433 | 380 | 402 | 293 | 470 | 273 | 411 | 383 | 180 | 140 | 129 | 108 | 163 | 218 | 62 | 234 | 252 |
| Labelled Cell Count | 115 | 160 | 233 | 230 | 293 | 362 | 490 | 500 | 467 | 515 | 382 | 566 | 274 | 417 | 389 | 195 | 152 | 145 | 108 | 163 | 218 | 62 | 234 | 252 |
Yeast GFP Assignment
Protein Abundance
| Screen | WT1 | WT2 | WT3 | RAP60 | RAP140 | RAP220 | RAP300 | RAP380 | RAP460 | RAP540 | RAP620 | RAP700 | HU80 | HU120 | HU160 | rpd3Δ_1 | rpd3Δ_2 | rpd3Δ_3 | AF100 | AF140 | AF180 |
|---|---|---|---|---|---|---|---|---|---|---|---|---|---|---|---|---|---|---|---|---|---|
| Mean Cell GFP Intensity (1e-4) | 5.9 | 7.4 | 7.3 | 6.2 | 6.5 | 5.6 | 5.3 | 5.4 | 5.1 | 4.9 | 4.4 | 4.4 | 7.8 | 7.9 | 7.8 | 10.0 | 10.4 | 9.9 | 6.0 | 8.0 | 8.5 |
| Std Deviation (1e-4) | 0.7 | 1.2 | 2.6 | 1.4 | 2.0 | 1.2 | 1.3 | 1.5 | 1.7 | 1.7 | 1.3 | 0.8 | 1.2 | 1.1 | 1.1 | 1.8 | 1.9 | 1.8 | 0.7 | 1.3 | 1.4 |
| Intensity Change (Log2) | – | – | – | -0.23 | -0.16 | -0.37 | -0.46 | -0.44 | -0.51 | -0.58 | -0.74 | -0.72 | 0.1 | 0.11 | 0.09 | 0.46 | 0.52 | 0.44 | -0.28 | 0.14 | 0.23 |
Localization Change
| Localization | RAP60 | RAP140 | RAP220 | RAP300 | RAP380 | RAP460 | RAP540 | RAP620 | RAP700 | HU80 | HU120 | HU160 | rpd3Δ_1 | rpd3Δ_2 | rpd3Δ_3 |
|---|---|---|---|---|---|---|---|---|---|---|---|---|---|---|---|
| Cortical Patches | 0 | 0 | 0 | 0 | 0 | 0 | 0 | 0 | 0 | 0 | 0 | 0 | 0 | 0 | 0 |
| Bud | 0 | 0 | 0 | 0 | 0 | 0 | 0 | 0 | 0 | 0 | 0 | 0 | 0 | 0 | 0 |
| Bud Neck | 0 | 0 | 0 | 0 | 0 | 0 | 0 | 0 | 0 | 0 | 0 | 0 | 0 | 0 | 0 |
| Bud Site | 0 | 0 | 0 | 0 | 0 | 0 | 0 | 0 | 0 | 0 | 0 | 0 | 0 | 0 | 0 |
| Cell Periphery | 0 | 0 | 0 | 0 | 0 | 0 | 0 | 0 | 0 | 0 | 0 | 0 | 0 | 0 | 2.8 |
| Cytoplasm | 1.1 | -0.2 | -3.6 | -5.8 | -6.5 | -8.7 | -8.6 | -10.2 | -10.3 | 1.8 | 2.3 | 2.1 | -0.7 | 0 | -0.8 |
| Endoplasmic Reticulum | 0 | 0 | 0 | 0 | 0 | 0 | 0 | 0 | 0 | 0 | 0 | 0 | 0 | 0 | 0 |
| Endosome | 0 | 0 | 0 | 0 | 0 | 0 | 0 | 0 | 0 | 0 | 0 | 0 | 0 | 0 | 0 |
| Golgi | 0 | 0 | 0 | 0 | 0 | 0 | 0 | 0 | 0 | 0 | 0 | 0 | 0 | 0 | 0 |
| Mitochondria | 0 | 2.9 | 6.0 | 8.7 | 8.3 | 9.9 | 0 | 0 | 0 | 0 | 0 | 0 | 0 | 0 | 0 |
| Nucleus | 0 | 0 | 0 | 0 | 0 | 0 | 0 | 0 | 0 | 0 | 0 | 0 | 0 | 0 | 0 |
| Nuclear Periphery | 0 | 0 | 0 | 0 | 0 | 0 | 0 | 0 | 0 | 0 | 0 | 0 | 0 | 0 | 0 |
| Nucleolus | 0 | 0 | 0 | 0 | 0 | 0 | 0 | 0 | 0 | 0 | 0 | 0 | 0 | 0 | 0 |
| Peroxisomes | 0 | 0 | 0 | 0 | 0 | 0 | 0 | 0 | 0 | 0 | 0 | 0 | 0 | 0 | 0 |
| SpindlePole | 0 | 0 | 0 | 0 | 0 | 0 | 0 | 0 | 0 | 0 | 0 | 0 | 0 | 0 | 0 |
| Vacuole | 0 | 0 | 3.2 | 3.2 | 4.6 | 6.0 | 4.8 | 5.0 | 3.4 | 0 | 0 | 0 | 0 | 0 | 0 |
External localization resources
Images






























Protein Concentration and Protein Localization Data
| R1 | R2 | R3 | ||||||||||||||||
|---|---|---|---|---|---|---|---|---|---|---|---|---|---|---|---|---|---|---|
| G1 Pre-START | G1 Post-START | S/G2 | Metaphase | Anaphase | Telophase | G1 Pre-START | G1 Post-START | S/G2 | Metaphase | Anaphase | Telophase | G1 Pre-START | G1 Post-START | S/G2 | Metaphase | Anaphase | Telophase | |
| Concentration | 2.9958 | 3.6647 | 3.1233 | 2.8488 | 2.3801 | 2.9698 | 1.5087 | 2.7771 | 2.7045 | 2.2129 | 2.2702 | 2.3797 | 0.5499 | 1.6438 | 1.4577 | 0.9659 | 1.8264 | 1.1453 |
| Actin | 0.0395 | 0.0002 | 0.0148 | 0.0028 | 0.0068 | 0.0005 | 0.0518 | 0.002 | 0.0093 | 0.0001 | 0.0003 | 0.0026 | 0.0041 | 0.0006 | 0.0097 | 0.026 | 0 | 0.0001 |
| Bud | 0.0003 | 0.0002 | 0.0002 | 0.0004 | 0.0061 | 0.0001 | 0.0018 | 0.0076 | 0.0005 | 0.0001 | 0.0001 | 0.0017 | 0.0001 | 0.0022 | 0.0001 | 0.0032 | 0 | 0 |
| Bud Neck | 0.0019 | 0.0001 | 0.0003 | 0.0006 | 0.001 | 0.0009 | 0.0036 | 0.0002 | 0.0004 | 0.0002 | 0.0004 | 0.0015 | 0.0002 | 0.0008 | 0.0002 | 0.0011 | 0.0002 | 0.0005 |
| Bud Periphery | 0.0004 | 0.0001 | 0.0002 | 0.0007 | 0.0089 | 0 | 0.002 | 0.0042 | 0.0003 | 0 | 0.0001 | 0.0021 | 0.0001 | 0.0006 | 0.0001 | 0.0038 | 0 | 0 |
| Bud Site | 0.0013 | 0.0024 | 0.0005 | 0.0022 | 0.0073 | 0.0001 | 0.0182 | 0.0031 | 0.0009 | 0.0001 | 0.0003 | 0.0007 | 0.0001 | 0.0075 | 0.0004 | 0.0068 | 0 | 0 |
| Cell Periphery | 0.0001 | 0.0002 | 0.0001 | 0.0001 | 0.0002 | 0 | 0.0005 | 0.0001 | 0 | 0 | 0 | 0.0001 | 0 | 0.0001 | 0 | 0.0002 | 0 | 0 |
| Cytoplasm | 0.7472 | 0.8952 | 0.8534 | 0.7887 | 0.7399 | 0.8838 | 0.6225 | 0.9381 | 0.9293 | 0.8681 | 0.8967 | 0.868 | 0.8568 | 0.9206 | 0.9217 | 0.8422 | 0.9556 | 0.9598 |
| Cytoplasmic Foci | 0.0101 | 0.004 | 0.0089 | 0.0123 | 0.0111 | 0.0066 | 0.0724 | 0.0058 | 0.0075 | 0.0072 | 0.015 | 0.019 | 0.007 | 0.0037 | 0.0042 | 0.0185 | 0.0039 | 0.0053 |
| Eisosomes | 0.0003 | 0 | 0.0001 | 0.0001 | 0.0001 | 0 | 0.0011 | 0 | 0 | 0 | 0 | 0 | 0.0001 | 0 | 0 | 0.0002 | 0 | 0 |
| Endoplasmic Reticulum | 0.0052 | 0.0015 | 0.0024 | 0.0004 | 0.0035 | 0.0011 | 0.0052 | 0.0013 | 0.0023 | 0.0008 | 0.0038 | 0.0022 | 0.0039 | 0.0022 | 0.0025 | 0.0062 | 0.0018 | 0.0014 |
| Endosome | 0.0162 | 0.0012 | 0.0084 | 0.0067 | 0.014 | 0.0018 | 0.0458 | 0.0008 | 0.0076 | 0.0136 | 0.0202 | 0.019 | 0.0046 | 0.0026 | 0.002 | 0.0154 | 0.0044 | 0.0021 |
| Golgi | 0.0037 | 0.0001 | 0.0017 | 0.0081 | 0.0036 | 0.0001 | 0.0184 | 0.0002 | 0.0053 | 0.0078 | 0.0098 | 0.0097 | 0.001 | 0.0006 | 0.0004 | 0.006 | 0.0001 | 0 |
| Lipid Particles | 0.0027 | 0.0001 | 0.0011 | 0.0285 | 0.0015 | 0 | 0.015 | 0.0015 | 0.0031 | 0.0012 | 0.0302 | 0.0147 | 0.004 | 0.0005 | 0.0002 | 0.0035 | 0 | 0 |
| Mitochondria | 0.0019 | 0.0001 | 0.0013 | 0.0442 | 0.0199 | 0.0001 | 0.0176 | 0.0017 | 0.0026 | 0.0249 | 0.0032 | 0.0124 | 0.0007 | 0.0004 | 0.0001 | 0.0077 | 0.0001 | 0.0001 |
| None | 0.1166 | 0.0914 | 0.0923 | 0.005 | 0.1121 | 0.0951 | 0.0549 | 0.0273 | 0.0238 | 0.0618 | 0.0067 | 0.0151 | 0.0955 | 0.0492 | 0.0538 | 0.0286 | 0.0216 | 0.0212 |
| Nuclear Periphery | 0.0232 | 0.0005 | 0.0015 | 0.0003 | 0.0105 | 0.0007 | 0.0032 | 0.0007 | 0.001 | 0.0008 | 0.0024 | 0.0023 | 0.0063 | 0.0009 | 0.0009 | 0.0047 | 0.0019 | 0.001 |
| Nucleolus | 0.0007 | 0 | 0.0001 | 0.0011 | 0.0017 | 0 | 0.0009 | 0.0002 | 0 | 0 | 0.0002 | 0.001 | 0.0001 | 0.0002 | 0 | 0.0009 | 0 | 0 |
| Nucleus | 0.015 | 0.002 | 0.0033 | 0.0033 | 0.034 | 0.0079 | 0.0039 | 0.0022 | 0.0031 | 0.0052 | 0.0047 | 0.0123 | 0.0112 | 0.0038 | 0.0026 | 0.0072 | 0.0086 | 0.0073 |
| Peroxisomes | 0.0013 | 0 | 0.0076 | 0.0926 | 0.0048 | 0.0001 | 0.0363 | 0.0011 | 0.0015 | 0.006 | 0.0029 | 0.006 | 0.0018 | 0.0003 | 0.0001 | 0.0091 | 0 | 0 |
| Punctate Nuclear | 0.0105 | 0.0003 | 0.001 | 0.001 | 0.0074 | 0.0008 | 0.0078 | 0.0009 | 0.0007 | 0.0003 | 0.0007 | 0.0044 | 0.0011 | 0.0015 | 0.0004 | 0.006 | 0.0005 | 0.0007 |
| Vacuole | 0.0011 | 0.0004 | 0.0006 | 0.0007 | 0.004 | 0.0003 | 0.0146 | 0.0006 | 0.0007 | 0.0013 | 0.0018 | 0.0038 | 0.0009 | 0.0015 | 0.0004 | 0.0018 | 0.001 | 0.0004 |
| Vacuole Periphery | 0.0009 | 0 | 0.0001 | 0.0003 | 0.0016 | 0.0001 | 0.0027 | 0.0002 | 0.0003 | 0.0004 | 0.0006 | 0.0014 | 0.0005 | 0.0001 | 0.0001 | 0.0008 | 0.0002 | 0.0001 |
Sequencing Data
| R1 | R2 | |||||||||
|---|---|---|---|---|---|---|---|---|---|---|
| G1 Post-START | S/G2 | Metaphase | Anaphase | Telophase | G1 Post-START | S/G2 | Metaphase | Anaphase | Telophase | |
| Gene Expression | 23.3889 | 26.2378 | 16.4274 | 25.957 | 16.0543 | 35.7514 | 30.8814 | 27.977 | 29.7917 | 28.0878 |
| Translational Efficiency | 1.3922 | 1.0411 | 1.267 | 0.931 | 1.7071 | 1.2201 | 1.0703 | 1.1138 | 1.2522 | 1.2327 |
Hit Data
| Dataset | Hit |
|---|---|
| Protein Concentration | ✘ |
| Protein Localization | ✘ |
| Gene Expression | ✘ |
| Translational Efficiency | ✘ |
Endocytosis
| Temp | Actin Patch (Sac6-tdTomato) | Cortical Patch (Sla1-GFP) | Late Endosome (Snf7-GFP) | Vacuole (Vph1-GFP) |
|---|---|---|---|---|
| 37℃ | ||||
| RT |
Cell Cycle Omics
CYCLoPs (Ygr111w-GFP)
| Gene / Allele | Actin Patch (Sac6-tdTomato) | Cortical Patch (Sla1-GFP) | Late Endosome (Snf7-GFP) | Vacuole (Sac6-tdTomato) |
|---|
| Gene | Images |
|---|
| Gene | Images |
|---|
Images are not yet available
Images are not yet available